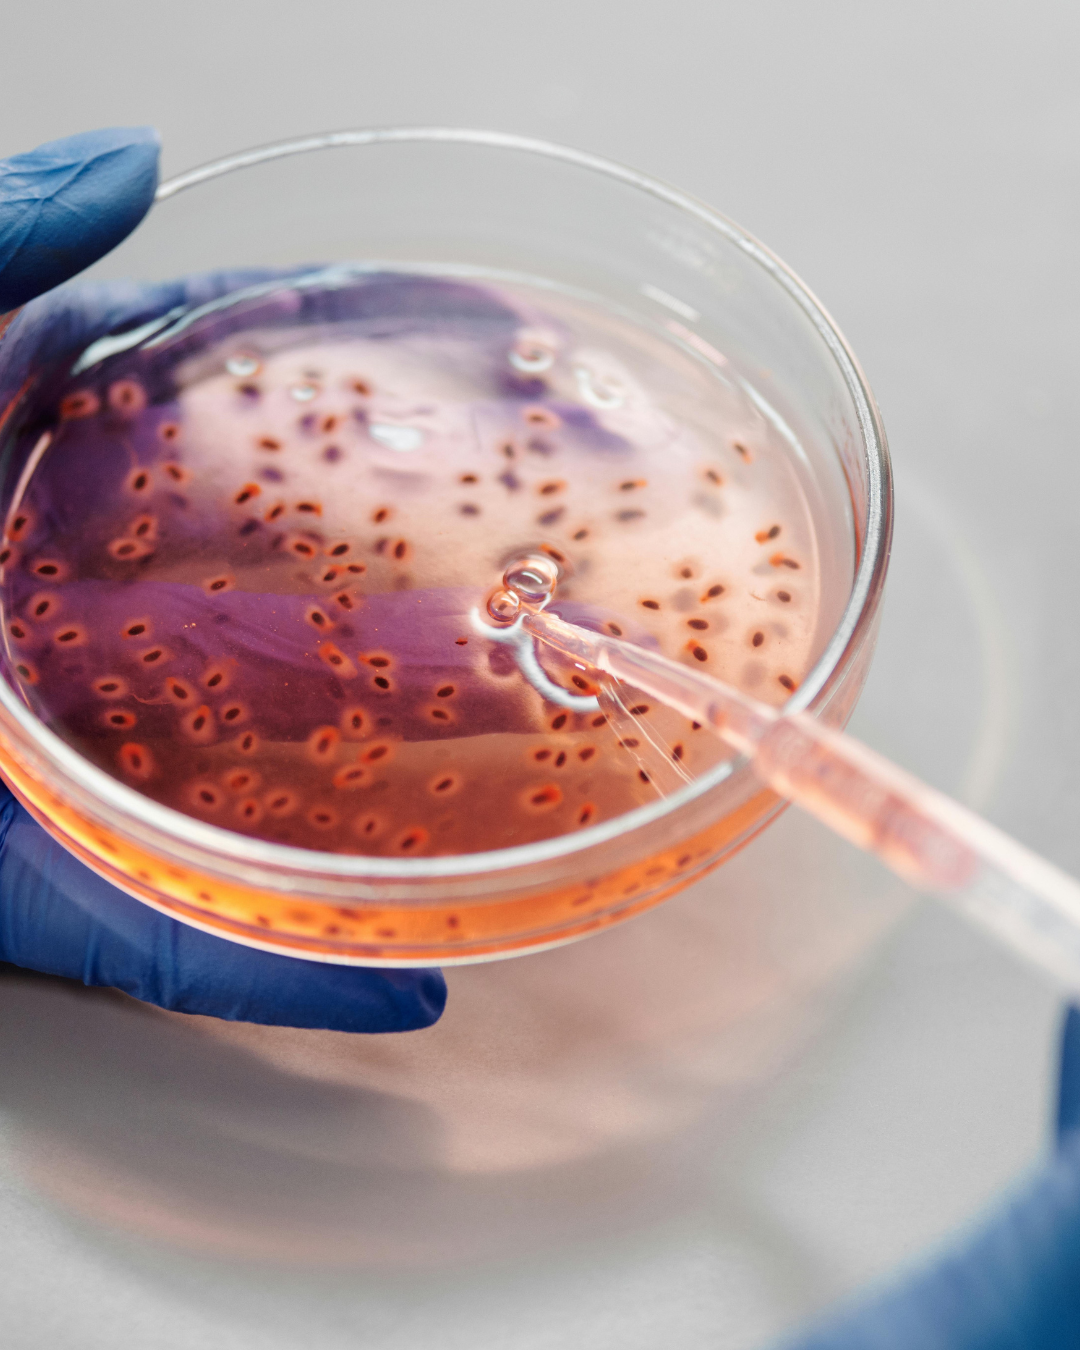
Drug Discovery Icon

From Classroom Theory to Lab Confidence
Not just certificates—gain skills that open doors to research and biotech.
"We aim at inspiring our trainees to explore more, master more, innovate more, and excel more in their respective journeys." — Dr. Navodipa Bhattacharya, PhD. (Founder)
Training Programs Overview

Molecular Biology
Master DNA cloning, PCR, gene expression, and CRISPR techniques.

Proteomics
Learn pro level LC–MS/MS and Western workflows to interpret proteomes.
Cell Culture
Hands-on aseptic technique, passaging, and cryopreservation.

Genetic Engineering
Master CRISPR design, delivery, and validation for engineered cell lines.

Drug Discovery
Develop assays, screening, and ADMET essentials for better leads.

Bioinformatics
Build omics pipelines in Python/R with publication-ready visuals.
Stay Updated on Admissions
Empowering Future Scientists — One Discovery at a Time
At BioGyan, we believe every student has the potential to change the world — but only if they’re given the tools to explore, experiment, and dream.
Discover Our Vision →Our Mission
To make advanced biology accessible, exciting, and hands-on for students across India — long before college.
Break the Stereotype
Science isn’t just textbooks. It’s curiosity, creativity, and real-world impact.
Build Real Skills
From DNA extraction to PCR, students learn techniques used in global labs.
Launch Careers Early
We help students discover careers they didn’t know existed — like bio-entrepreneurship or environmental genomics.
Why Students Choose BioGyan
We don’t just teach biology — we ignite passion.
“I used to think biology was boring. After my first workshop at BioGyan, I knew I wanted to become a geneticist. Now I’m building my own startup in synthetic biology.”
— Priya M., 12th Grade, Chennai
Join Your First Workshop →